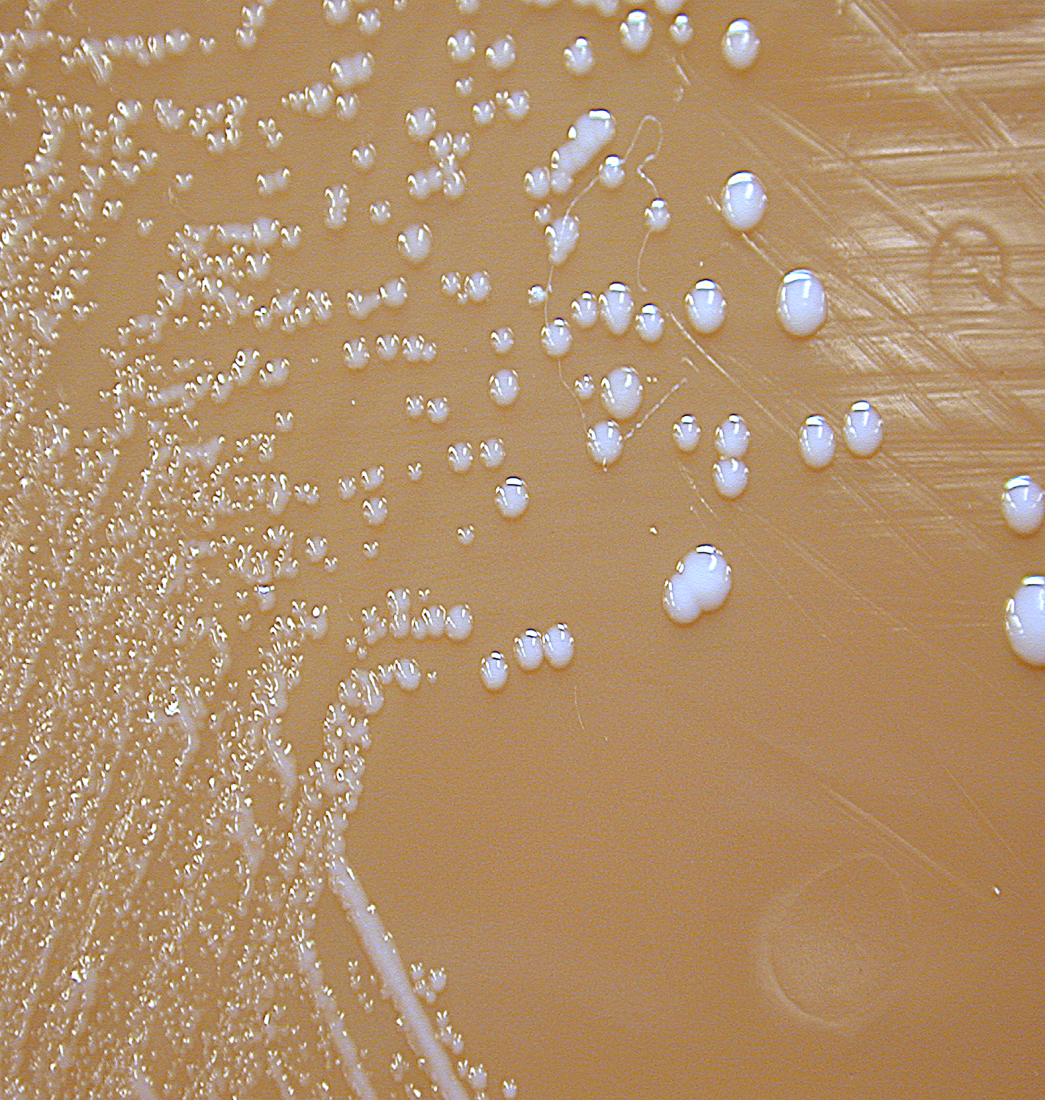

Stenotrophomas maltophila (aka Pseudomonas maltophila
Gram negative
Aerobic, catalase positive, motile, ubiquitous bacilli
Grows on MacConkey’s agar.
VF: Metallo B-lactamases
Causes pneumonia, UTI, & bacteremia (in AIDs patients)
Treat with Cotrimoxazole + ticarcillin & remove the parasite.
Bartonella
- quintana
- henselae
- bacilliformis
Gram-negative, facultative intracellular, opportunistic, microaerobic, bacilli
Transmitted via ticks, fleas, sandflies
quintana= causes Trench fever that’s transmitted by lice (5-day fever, severe headache, periorbital pain, hyperesthesia)
Use the Weil-Felix test
henselae= causes cat-scratch disease (fever, enlarged/tender lymph nodes, papules/pustules
bacilliformis= causes carrion disease via sandflies, Oroya fever (fever, headache, muscle aches, abdominal pain, severe anemia) & Veruga peruana(lesions/nodular growths under the skin & red/purple lesions on the surface of the skin)
The bacteria that causes cat-scratch disease (fever, enlarged/tender lymph nodes, papules/pustules

Bartonella henselae
The two bacteria that could cause these symptoms:
Causes Trench fever that’s transmitted by lice (5-day fever, severe headache, periorbital pain, hyperesthesia)
Use the Weil-Felix test
Causes cat-scratch disease (fever, enlarged/tender lymph nodes, papules/pustules

Bartonella quintana & Bartonella henselae
Which bacteria causes carrion disease via sandflies, Oroya fever (fever, headache, muscle aches, abdominal pain, severe anemia) & Veruga peruana(lesions/nodular growths under the skin & red/purple lesions on the surface of the skin)

Bartonella bacilliformis
Gardenella vagenalis

Gram-variable, facultatively anaerobic, non-sporing, non-motile, coccobacilli
Grows on chocolate agar
Selective media = colistinoxonilic acid blood agar
Causes bacterial vaginosis (foul/fishy smelling, frothy grey/yellow/green discharge, positive whiff test, & clue cells)
Treat metronidase or clindamicin
Capnocytophage bacteria
- canimosus
Gram-negative bacillus
Causes sepsis in asplenic/AIDS/elderly patients via dog bites
Treat= 3rd gen cephalosporins
Calymatobacterium granulomatis (k. granulomatis)

Gram-negative encapsulated bacilli
Cause granuloma inguinale/Donovanosis (STI) & beefy red ulcers with rolled edges
Tests= Look for Donovan’s bodies on Wright’s stain (gram neg encapsulated bacilli in the cytoplasm of mononuclear phagocytes/histocytes (intracellular inclusions)
Actinobacillus
Gram-negative, non-motile, non-sporing, facultative aerobic, bacilli
causes= Sinusitis & bronchopneumonia
Features: ferments carbs without making gas & it’s a part of the HACEK group (can cause endocarditis)
Treat= it’s susceptible to B-lactam antibiotics
A 22-year-old female reported to the gyneacologist with complaints of foul-smelling vaginal discharge causing pruritis. Thinking she was suffering from a yeast infection, she was treated for the same but to no avail. The discharge was positive with 10%KOH. On microscopy, gram variable bacilli within epithelial cells were noticed.
Which among the following are the characteristic microscopic cells observed that confirm the diagnosis for the above ?
Koilocytes
HP bodies
Negri bodies
Clue cells
Giant cells
Based on your answer to the previous question;
Which among the following is the predominant causative agent seen as a gram variable bacilli causing the above infection?
Trichomonas vaginalis
Actinobacillus moniliformis
Bacteroides fragilis
Gardnerella vaginalis
Candida albicans
- Clue cells
- Gardenella vaginalis
A 56 year old Caucasian man was transferred to a tertiary care hospital in Winnipeg, Manitoba from a peripheral hospital with symptoms of congestive heart failure, dyspnoea, slight chest pressure and fever. His blood culture revealed a gram negative, pleomorphic bacillus belonging to the HACEK group that was found to be resistant to erythromycin. The patient’s condition was diagnosed as infective endocarditis
Which among the following organism is the etiological agent for the above case?
Actinobacillus hominis
Streptococcus pneumoniae
Hemophilus parainfluenzae
Cardiobacterium hominis
Bartonella quinatana
Actinobacillus hominis
A 35 year old sexually promiscuous male reported to the STD department with clinical manifestations of genital lesions with a rolled granulomatous edge. The exudate from the lesions were obtained and on microscopy revealed intracellular inclusions in histiocytes
Which among the following are the ‘intracellular inclusions’ specific to this organism, causing granuloma inguinale?
Which among the following is the etiological agent for the above condition?
HP bodies
Donovan bodies
Negri bodies
Cowdry type A
Cowdry type B
Gardnerella vaginalis
Hemophilus ducreyi
Calymatobacterium granulomatis
Actinobacilus moniliformis
Capnocytophaga canimorsis
- Donovan bodies
- Calymatobacterium granulomatis
Cardiobacterium
- c. hominis
Gram-negative pleomorphic bacilli
Features= A part of the HACEK group (can cause valvular endocarditis) & resistant to erythromycin
Treat= use penicillin or cephalosporins (if resistant to penicillin)
Brucella bacteria
- abortus
- melitensis
- suis
- canis
Gram-negative, facultative intracellular, zoonotic coccobacilli
Brucella abortus: via cattle/unpasteurized cow’s milk (rare & stains poorly = small gram-negative coccobacilli
Brucella melitensis: via goats/sheep (common) grows slowly on standard media showing pinpoint, smooth, & translucent colonies that are not hemolytic at 48hrs
Brucella suis: via pigs/swine (rare & severe/prolonged) causing pancytopenia & destructive lesions of lymphoreticular organs (reno/hepatomegaly), intermittent fever, non-productive cough, depression, malaise, chills, & anorexia arthralgias
IP~ up to 60 days
Brucella canis via dogs (rare) causes a mild suppurative febrile infection
Characteristics of Brucella “BIO GEL”

potential BIOTERRORIST agent
Granulocyte production
NO EXOTOXIN
acute Lymphadenitis

Francisella tulareusis
Gram-negative, strictly aerobic, non-motile, facultative intracellular parasite, encapsulated zoonotic coccobacilli
via ticks from rabbits/muskrats)
2 forms= ulderoglandular (common) & pneumonic (pulmonary lethal)
Tests: A slow grower (48hrs) that is fastidious (it needs sulfhydryl aka cysteine), grows on chocolate agar & buffered charcoal-yeast extract agar
It’s urease negative, so it doesn’t grow on MacConkey’s
Yersinia bacteria
- Enteric
- Pseudotuberculosis
- Pestis
Gram-negative bacilli
y. Enteric (facultative anaerobe): transmitted via animals, fish, fruits/veggies, & water
Affects the Gi (mimics appendicitis)
Tests: Selective media is Cefsulodin-irgason novobiocin agar( red-bulls eye)
it also grows on Christensen’s urease agar (growing pink colonies = urease positive) & MacConkey’s agar (flat/colourless/pale = DOESN’T ferment lactose)
y. Pseudotuberculosis (similar to Enteric but causes inflamed lymph nodes)
y. Pestis: unusual bipolar staining coccobacilli with capsules & a safety pin appearance
transmitted via rat flea bites
Virulence factors: capsular & envelope (to protect from phagocytosis and promote intracellular growth)
Causes the plague:
-bubonic (bacillus multiplies in the flea bite and causes necrosis and swelling forming bubos in the axilla/groin)
- Septicemia (massive overgrowth from the intravascular coagulation causing subcutaneous hemorrhage and purpura (black plague)
- Pneumonis (very contagious & fatal without treatment)
Treat = streptomycin, tetracycline, or chloramphenicol
Prevent = Killed/attenuated vaccine & quarantine
Pasturella Multicoda
gram-negative coccobacilli with bipolar staining
Transmits via animal bites/scratches (causing local abscesses that spread to joints, bones, and lymph nodes
Causes: Acute/painful cellulitis (within 24hrs of the bite)
It’s opportunistic in AIDS patients & it’s tested on a blood agar
Treat with penicillin and tetracyline
Clostridium bacteria
- tetani
- botulin
TETANI: gram-positive obligate anaerobic, motile spore-forming (terminal aka drumstick) bacteria
Bacteria replicated in a wound —> forms
tetanosporing (gets to CNS via retrograde axonal transport to cleave synaptobrevin (SNARE) and block GABA/Glycine release so alpha motor neurons are constantly actively causing spastic paralysis)
&
Tetanolysin does hemolysis and cardiotoxic effects
Generalized = trismus (lock-jaw), risus sardonicus (flexed face), opisthotonus (arched back)
Localized = muscle rigidity at the spore site
Cephalic = head wound
neonatal= usually fatal or leaves developmental defects
Treat: Benzodiazepines to relieve spasms & Metronidazole, passive immunity (human tetanus immunoglobulin to lessen severity), & active immunity
BOTULIN: gram-positive strict anaerobic, motile spore-forming bacilli
Strains A,B,E,F = human disease
Food born: In the USA type A (West) & B (East), E (Fish) toxin ingestion in cooling food (preformed toxin) that impairs peripheral cholingeric synpases at the neuro-muscular junction prevents )
Wound: Spores are associated with IV injection of black tar heroin (no Gi symptoms)
Infant: Spores in wild honey cause floppy baby syndrome
Look for bilateral cranial nerve palsy, blurred vision, no fever/sensory deficits
Treat: Antisera A,B,E & supportive therapy (made from horses)
Bacillus anthracis

gram-positive, bamboo-shaped, medusa-head colonies, spore-forming, non-motile aerobic bacilli
Cutaneous= painless pruritic papule that develops into a painless necrotic black eschar with surrounding non-pitting edema
Treat with ciprofloxacin & doxycycline
Gi (rare)= causes oropharyngeal anthrax (febrile neck swelling from cervical adenopathy, dysphagia, and hoarseness) & intestinal anthrax (hemorrhagic diarrhea and septicemia, which are often fatal)
Inhaled (Woolsorter’s disease) = an occupational hazard of dealing with sheep or animal hides; it’s a potential bioterrorist agent because it’s highly contagious and has a short IP (less than a week)
- hemorrhagic mediastinal (widening mediastinum)
- multilobar pneumaonia
- high hemorrhagic pleural effusion
- early bacteremia (very fatal)
- secondary meningoencephalitis (very fatal)
(Gi + inhaled) Treat with multidrug therapy= IV ciprofloxacin & doxycycline, + Rifampin/or/clindamycin/or/vancomycin
Prevent = Human vaccine (protective agent and adjuvant alum) can never cause the disease
gram-positive strict anaerobic, motile spore-forming bacilli associated with black tar heroin & floppy baby syndrome

Clostridium botulism
Clostridium bacteria
- tetani
- botulin
TETANI: gram-positive obligate anaerobic, motile spore-forming (terminal aka drumstick) bacteria
Bacteria replicated in a wound —> forms
tetanosporing (gets to CNS via retrograde axonal transport to cleave synaptobrevin (SNARE) and block GABA/Glycine release so alpha motor neurons are constantly actively causing spastic paralysis)
&
Tetanolysin does hemolysis and cardiotoxic effects
Generalized = trismus (lock-jaw), risus sardonicus (flexed face), opisthotonus (arched back)
Localized = muscle rigidity at the spore site
Cephalic = head wound
neonatal= usually fatal or leaves developmental defects
Treat: Benzodiazepines to relieve spasms & Metronidazole, passive immunity (human tetanus immunoglobulin to lessen severity), & active immunity
BOTULIN: gram-positive strict anaerobic, motile spore-forming bacilli
Strains A, B, E, F = human disease
Food born: In the USA, type A (West) & B (East), E (Fish) toxin ingestion in cooling food (preformed toxin) that impairs peripheral cholinergic synapses at the neuro-muscular junction prevents )
Wound: Spores are associated with IV injection of black tar heroin (no Gi symptoms)
Infant: Spores in wild honey cause floppy baby syndrome
Look for bilateral cranial nerve palsy, blurred vision, no fever/sensory deficits
Treat: Antisera A, B, E & supportive therapy (made from horses)
What’s the causal agent?

Cutaneous anthrax (Bacillus anthracis)
Bacillus cereus
Gram-positive, saprophyte (lives in soil, water, & veggies), motile, bacilli
Causes food poisoning but doesn’t have a glutamic acid capsule
Emetic form (like s.aureus) = nausea, vomiting, & abdominal cramps, caused by a heat-stable toxin in starchy foods (i.e. fried/overnight rice & cooking and cooling preforms the toxin)
Diarrheal = from ingesting a heat-labile toxin in its vegetative form (toxins are produced in the upper Gi (meat, veg, & sauces)
Test: Blood agar shows anthracoid colonies (10^8 = significant)
Treat: self-limiting unless it’s severe, then use vancomycin/or/clindamycin + aminoglycoside


